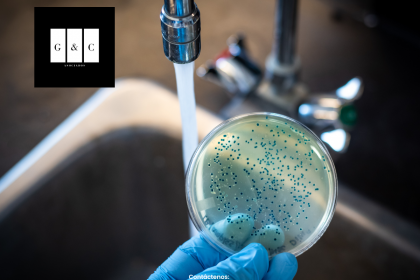

Independientemente de los graves problemas que está causando en las grandes ciudades del país
la escasez de agua, se añade otro también muy importante que se relaciona con la calidad y
pureza de este recurso no renovable. Si bien la falta de agua es hoy en día un fenómeno de notoria
trascendencia negativa que hace crisis para la actividad de millones de personas, ahora la
probabilidad de que el agua disponible se encuentre contaminada, encara la intervención puntual,
inteligente y determinante de las autoridades de los tres órdenes de gobierno para dar la certeza a
los habitantes de que no es así.
En este sentido, amables lectores, debemos destacar que el Instituto Nacional de Investigaciones
Nucleares (ININ) anunció recientemente que llevará a cabo estudios a escala nacional en acuíferos
utilizados para el abastecimiento de agua potable, con el fin de detectar niveles de contaminación
de materiales radiactivos que pudieran estar presentes en el agua que consumen las personas.
El organismo federal reconoce que no existe conocimiento suficiente sobre la condición
radiológica del recurso hídrico en el país debido a que no se cuenta ni con el personal adecuado ni
con laboratorios especializados en la materia y que para subsanar esto, adquirirá equipo especial
para conocer el posible riesgo en la población por la concentración de elementos radiactivos
naturales presentes en pozos de la red de abastecimiento de agua potable. Subraya asimismo el
ININ que en la actualidad está bien documentado que la gran mayoría de problemas de salud
relacionados con el agua se deben a contaminación por microorganismos y, en mucha menor
medida, a contaminación química.
Sobre contaminación del agua por microorganismos, existe evidencia de un caso reciente que la
Comisión Nacional del Agua (Conagua) documentó hace poco en la presa Miguel Alemán, en el
municipio de Valle de Bravo, Estado de México. La dependencia federal localizó en el agua de ese
lugar materia fecal en grandes cantidades, lo que representa un riesgo para la salud comunitaria.
Otro caso inquietante que se debe resaltar, amables lectores, sobre contaminación acuífera es
que incluso el agua de lluvia ya no es potable en ninguna parte del mundo. A esta conclusión
llegaron investigadores de la Universidad de Estocolmo que encontraron presencia de sustancias
tóxicas en este tipo de agua, producidas por actividad humana que se propagan en la atmósfera y
pueden generar daños en la salud de las personas, tales como cáncer, infertilidad y aumento de
colesterol.
Todos los casos mencionados anteriormente confirman que no hemos sido capaces de cuidar
nuestro recurso hídrico y que por lo mismo enfrentamos situaciones no sólo de escasez de agua,
sino de que esta se encuentre contaminada, situación que las autoridades deben atender con
mucha eficiencia a través de presupuestos suficientes, pues entes que todo la salud de la
población es primordial.
Hasta la próxima, amables lectores.
Por: Alfredo Pérez Guzmán



